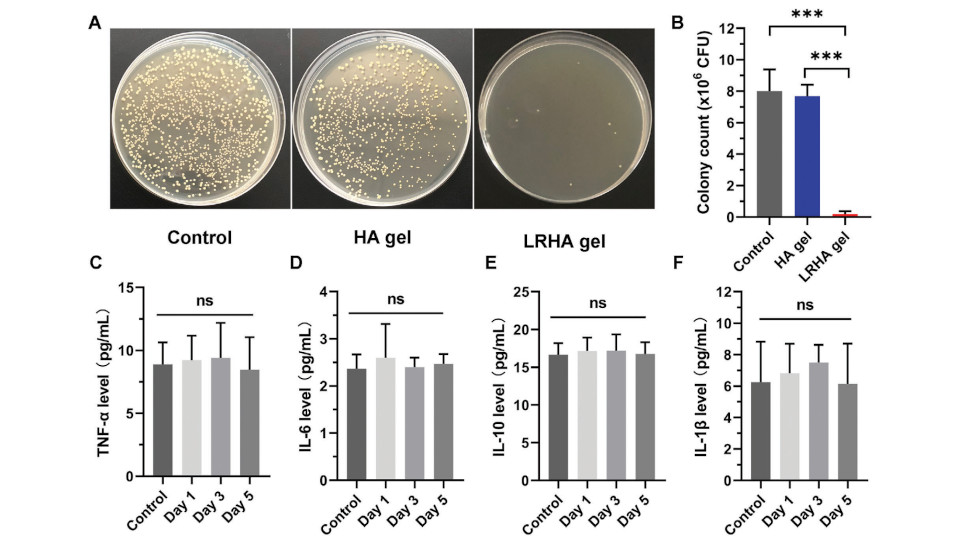

皮肤作为人体与周围环境的重要界面,在防止水分流失和阻止有害物质的入侵方面发挥着极其重要的作用。受损的皮肤无法阻止有害细菌侵入组织,造成伤口感染,甚至严重的组织损伤。传统的治疗方法在杀灭致病菌的同时,还会抑制有益菌的生长,从而破坏受损皮肤微生态系统的平衡。

近日,上海市第十人民医院的研究团队在期刊Advanced Science上发表了题为:Living Bacterial Hydrogels for Accelerated Infected Wound Healing 的研究论文。该研究合成了一种对不同细菌具有良好抑菌效果,且能保护有益细菌免受免疫系统伤害的水凝胶敷料。体外实验亦揭示该水凝胶敷料可减轻炎症细胞浸润,促进胶原沉积,加速伤口愈合。

水凝胶微球与一般水凝胶相比,具有许多独特的特性,包括可注射性、模块化和孔隙性。水凝胶微球封装细胞,通过物理限制保护细胞免受环境干扰,亦能防止封闭的活菌逃逸。
基于此,研究团队通过乳液聚合,将含有活菌的甲基丙烯酸明胶溶液共价交联,将罗伊氏乳杆菌(L. reuteri)封装到水凝胶微球中。并对L. reuteri的生存力进行测定,验证了制备的水凝胶微球(MHA-LR)适合细菌的生长。

进一步地,研究团队探讨了MHA-LR的特性。他们发现,MHA-LR凝胶体系具有快速凝胶化能力和网络的完整性及稳定性;含微球的水凝胶和不含微球的水凝胶之间没有显著差异;能阻止了细菌逃逸到当地环境中。这些结果表明含有活细菌的水凝胶在微球中具有良好的生物安全性,可以避免潜在的细菌感染。

罗伊氏乳杆菌是一种常见于人和动物体内的益生菌,调节免疫反应。罗伊氏乳杆菌可以产生乳酸来降低生存环境的pH值,从而抑制金黄色葡萄球菌等有害细菌的生长。此外,罗伊氏乳杆菌还能分泌一种名为罗伊氏素的抗菌药物,对抗革兰氏阳性菌和革兰氏阴性菌有效。
研究团队对MHA-LR进行体外抗菌试验。结果显示,MHA-LR对大肠杆菌、金黄色葡萄球菌和沙门氏菌的生长均有良好的抑制作用。
进一步地,他们用小鼠成纤维细胞作为模型进行活/死试验对MHA和MHA- lr的细胞相容性及毒副作用进行评价。结果证实了MHA-LR具有良好的生物相容性,对细胞生长和增殖无副作用,提示其有望在体内进一步应用。

接下来,研究团队以小鼠为模型,评价活菌水凝胶在体内的抗菌能力。结果显示,经罗伊氏乳杆菌水凝胶处理后,破损处皮肤的细菌生长情况得到良好抑制。此外,通过分析植入含有罗伊氏乳杆菌材料的小鼠炎症细胞因子,评价MHA-LR的生物相容性。结果显示,对照组与植入活菌水凝胶组的所有炎症因子仅有微小差异。
那么,MHA-LR对伤口愈合的实际作用如何呢?
研究团队建立了金黄色葡萄球菌全层皮肤创面模型进行评价水凝胶促进创面愈合的效果。采用数码相机拍摄图像,监测创面愈合过程。
他们发现,治疗10天后,LRHA治疗的伤口完全闭合,并被新的表皮组织覆盖;未治疗和使用HA治疗组仍有38%和24%的伤口未愈合。这些结果表明,LRHA在促进创面愈合中发挥重要作用,这与罗伊氏乳杆菌分泌的乳酸和抗菌药物的良好抗菌能力有关。

病理检查揭示各组创面愈合过程,结果显示,与对照组和HA组相比,LRHA组小鼠的伤口组织在治疗7天和10天后伤口长度更短,炎症细胞更少,毛囊数量更多,胶原占据区域比例更高,上皮层更薄。
此外,三组主要脏器保持了组织的完整性,没有异常的缺陷或损伤。这些结果表明,LRHA具有良好的抗菌能力和出色的促创面愈合性能,为临床创面修复提供了一种新的基于活菌的安全策略,具有潜在的应用前景。

总而言之,该团队成功地制备了一种不仅能保护细菌免受免疫系统的伤害,还能防止细菌逃逸到当地环境中的水凝胶微球敷料。体外实验验证了所制备的水凝胶具有良好的抑菌效果和生物相容性。体内实验进一步揭示LRHA可减轻炎症细胞浸润,促进胶原沉积,加速伤口愈合。该研究为临床创面修复提供了一种新的基于活菌的安全策略。
联科生物 产品支撑
联科生物专业从事ELISA试剂盒研发生产十余年,种类多样,质控严格,助力科研。更多信息请点击官方网站或与我们联系400-6721-600。
